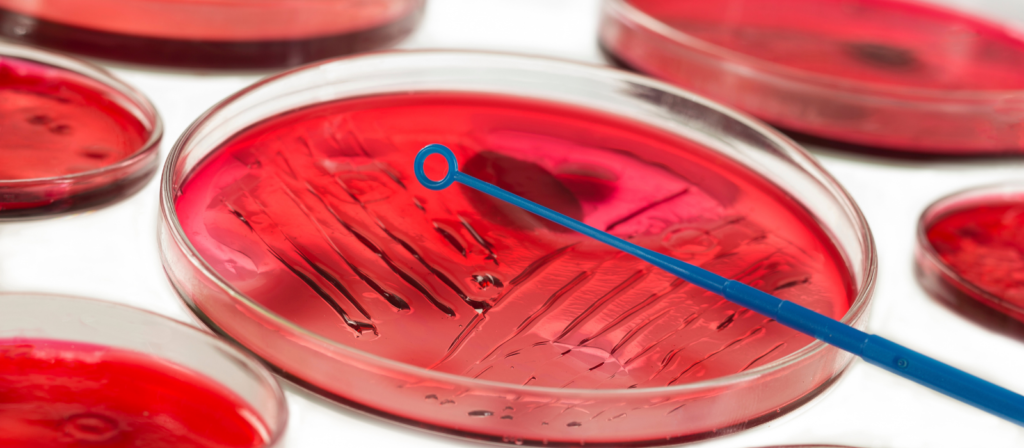
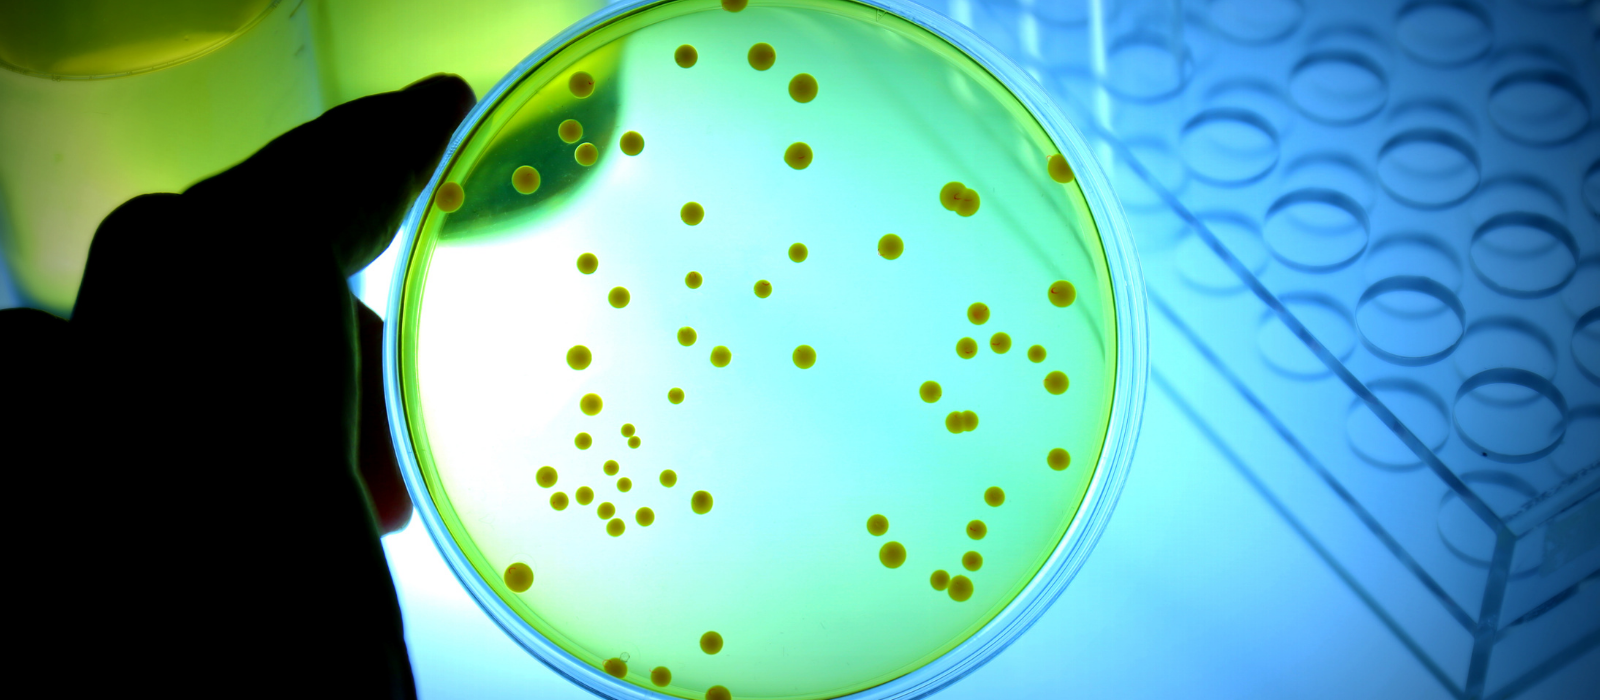

Vamos falar sobre o Caldo Verde Brilhante?
O caldo verde brilhante (BGB) é uma modificação do meio de cultura líquido de MacConkey para o isolamento de Enterobacteriaceae e foi formulado para obter a máxima recuperação de bactérias do grupo coli-aerogenes, enquanto inibe a maioria dos organismos gram-positivos que podem dificultar o desenvolvimento da bactérias procuradas.
Contém verde brilhante e bile como agentes inibitórios para organismos gram-positivos e lactose como fonte de carbono que é rapidamente dissimilada pelo grupo coli-aerógenes, principalmente por uma via heterofermentativa, levando à formação de gás
É marcadamente superior ao caldo MacConkey para a confirmação de Escherichia colia 44°C. O caldo BGB é composto de peptona, lactose, bílis de boi, verde brilhante e água destilada ou deionizada.
Como preparar o Caldo Verde Brilhante?
Este capítulo descreve a preparação do caldo verde brilhante. Os ingredientes são dissolvidos em água, distribuídos nos volumes necessários em frascos ou tubos e aquecidos a 100°C por 30 minutos.
Embora os meios de lactose sejam marcadamente menos sensíveis aos danos causados pelo calor do que aqueles que contêm glicose, o desempenho do meio em relação à seletividade e produtividade é muito mais consistente quando é descontaminado por pasteurização padronizada, conforme recomendado.
O “Caldo Verde Brilhante” é um meio de cultura usado em microbiologia para cultivar bactérias. Aqui está um resumo do processo de preparação:
Ingredientes: peptona, extrato de carne, cloreto de sódio, glicose, agar (opcional), corante verde brilhante, água destilada.
Passos:
- Misture peptona, extrato de carne, cloreto de sódio e glicose em água destilada.
- Adicione agar (se desejar em forma de gel) e aqueça até dissolver.
- Ajuste o pH para cerca de 7,2.
- Adicione corante verde brilhante.
- Se em forma líquida, divida em tubos de ensaio.
- Autoclave a 121°C por 15-20 minutos para esterilização.
- Se em forma de ágar, derreta antes de usar.
- Use o meio estéril para cultivar micro-organismos.
Siga práticas de laboratório seguras durante todo o processo.
Composição e Benefícios
A cor verde brilhante desse meio de cultura não é mera coincidência; ela é resultado da combinação de componentes selecionados com precisão para atender às necessidades metabólicas das culturas microbianas. Geralmente, o meio de cultura Caldo Verde Brilhante contém:
- Peptona: Fonte de nitrogênio e aminoácidos essenciais para o crescimento microbiano.
- Extrato de Carne: Fornecimento de nutrientes variados, como vitaminas e minerais.
- Lactose: Uma fonte de carbono que pode ser fermentada por muitos microrganismos.
- Verde Brilhante: O corante responsável pela coloração característica e, em alguns casos, pela inibição de certos micróbios, tornando o meio seletivo.
A combinação desses componentes cria um ambiente rico em nutrientes, que permite que os micróbios cresçam e se multipliquem. Além disso, a coloração verde brilhante auxilia na diferenciação de diferentes tipos de microrganismos, simplificando a identificação de culturas específicas.
Aplicações
O meio de cultura Caldo Verde Brilhante tem uma série de aplicações práticas em microbiologia:
- Identificação Microbiana: Devido à sua seletividade e à coloração intensa, ele é frequentemente usado para identificar e isolar bactérias patogênicas em amostras clínicas.
- Testes de Sensibilidade: É empregado para testar a sensibilidade de microrganismos a diferentes antimicrobianos, auxiliando na escolha de tratamentos eficazes.
- Pesquisa Ambiental: É utilizado para investigar a presença de micróbios em ambientes diversos, como solos e águas, auxiliando em estudos de biodiversidade microbiana.
- Indústria Alimentícia: No controle de qualidade de alimentos, o meio pode ser usado para detectar bactérias contaminantes.
Conclusão
O meio de cultura Caldo Verde Brilhante é uma ferramenta valiosa na caixa de instrumentos de microbiologistas e cientistas que exploram o mundo microscópico. Sua coloração vívida e composição inteligente oferecem um ambiente propício para o crescimento, tornando-o indispensável em laboratórios e pesquisas que envolvem a identificação e estudo de microrganismos diversos. À medida que a ciência avança, a mágica do Caldo Verde Brilhante continua a iluminar o caminho para descobertas microbiológicas emocionantes e inovadoras.
AVISO DE DIREITOS AUTORAIS: Todo o material deste blog, sendo proibida toda e qualquer forma de plágio, cópia, reprodução ou qualquer outra forma de uso.
Qualquer dúvida técnica sobre os equipamentos contidos no portfólio SPLABOR, entre em contato com o Departamento de Vendas (sp@splabor.com.br)

A Splabor é uma empresa líder no ramo de fabricação de equipamentos para laboratório, especializada em oferecer uma ampla variedade de equipamentos para laboratórios, materiais e produtos para laboratório de alta qualidade.